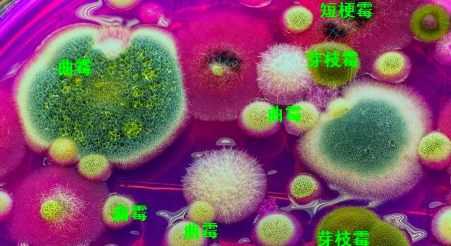

《生活中的霉菌官方版》是以现实生活中的霉菌为主题的益智类游戏,在生活中霉菌是无处不在的,有很多也是对人体有危害性的,这款游戏将让玩家霉菌的形成过程,也给玩家演示正确的除菌手段,在游戏中学习健康的生活方法。
游戏介绍
游戏具备联想力与探究能力培养的特色,游戏主题分为:小菌在哪里、霉菌培养实验室两种玩法。其中小菌在哪里主要是运用空间ARKit的技术,让使用者在真实空间中,看到虚拟的老旧房子,依据使用者对于霉菌的认知,找出房子里容易发霉的物品,以贴近生活的情境培养学习思考能力。霉菌培养实验室则包括三个小关卡,分别是认识及观察霉菌生长、一起培养小菌吧及AR桌游。内容包括观察霉菌生长、认识霉菌构造以及提供不同的变因让学生进行探究,变因包括:天数、水量、温度、浓度、水溶液种类等,培养学生的探究实验能力。最后运用AR桌游的攻防游戏,除可增进使用者的学习成效,也借此培养使用者表格阅读及分析能力。

游戏特色
1、顶级的游戏模式和专属的养成剧情,能够给你一个不一样的生活冒险乐趣和享受。
2、多种多样的冒险手段,将会带给你很多的选择,顶尖的游戏模式带给你更顶级的快感。
3、全新的模拟养成方式能够给你不同的精彩和享受,在不断的格斗之中来给你不同的乐趣。
游戏亮点
这款游戏采用了独特的元素打造,而且游戏的操作非常的简单

玩家需要去吞噬敌对的细腻,然后就可以分裂出更为强大的新生物
超过上百个游戏关卡,超多刺激的游戏内容在这里等玩家来体验
游戏的难度不大,新老玩家上手都很快;各种各样的病菌等你来观察
游戏评测
主打生活性元素为主题设计,玩法上融入了很多现实性的元素,让玩家能够在游戏中了解更多菌类知识;
主张寓教于乐的游戏模式,轻松有趣的游戏玩法让每个玩家都能够更好的学习和了解,每个过程都很形象。
银河竞逐苹果版
堕落之王手游中文版ios版
仙侠风云录手游ios版
三国英豪记ios版手游
三国幻世录苹果版
纪念碑谷3苹果免费版本
二次元纷争ios手游
口袋x妖怪苹果版
三剑豪2苹果版
三国战起来手机版苹果版
夏日甜心苹果版
消消陆战队2游戏ios版



小熊美发沙龙手机苹果游戏
全民西游2苹果版
地下城与冒险ios版
火影世界ios版
口袋妖怪xy手机版ios
仙侠奇缘ol苹果版手游
三剑豪手游苹果版
超能继承者苹果版
星辰之翼苹果bt版
王者h5手游ios版
马踏千军手游ios版
梦想江湖ios版手游
逍遥西游2变态服ios
少年悟空传手游ios版
口袋妖怪重制苹果果盘版
口袋妖怪3ds果盘版ios
御剑奇缘苹果版
逍遥西游ios变态版
御剑凌仙苹果版
花千骨ios果盘版
仙剑加强版苹果变态版
最三国bt苹果版
御剑情缘手游ios版
艾德尔冒险手游苹果版
剑舞者们快用苹果版
儿时的街机游戏
拼图游戏大全
原神
生活实用APP